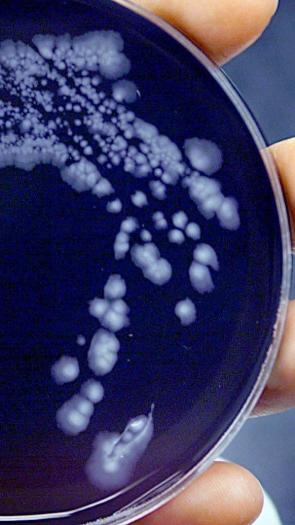
Antibiotica

Redacteur
Femke van der Laan
Femke is onder andere columnist, schrijver en voormalig eindredacteur van NPO Focus. Van haar hand verschenen de boeken Stad vol ballonnen en Aan de randen van de dag. Daarnaast presenteert ze sinds september 2022 vier dagen het radioprogramma Nooit Meer Slapen (VPRO).